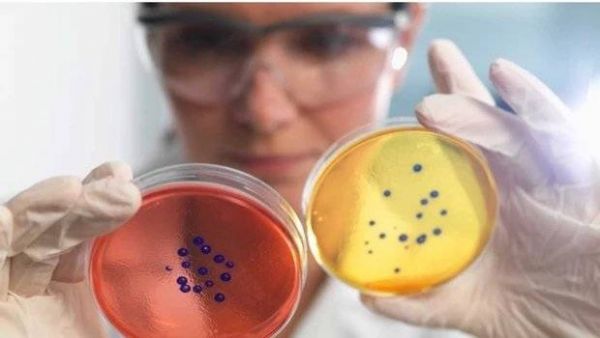

“吃货”拯救世界,细菌如何通过吃吃吃拯救地球?
本文来自微信公众号:造就(ID:xingshu100),作者:Gabrielle,审校:田晓娜,题图来自:视觉中国
我们有麻烦了:过度依赖化石燃料,对高碳足迹食品的喜爱,导致了破坏性的气候变化;“用后即弃”的社会模式,给大地和海洋造成了大量塑料污染;无法通过抗生素杀灭的致病微生物,造成了公共健康危机……
好消息是,在过去几年里,许多证据显示我们可以将二氧化碳从大气中清除,减缓气候变化;我们可以生产出优质且低碳的蛋白质;我们也可以清理污染,减少抗药性的影响。
此类潜在创举的共同要素是什么呢?细菌。虽然听起来不太现实,但我们未来的健康幸福或许取决于这些低调的微生物。
1. 健康
细菌可能会危害我们的健康,它们可以造成肺结核、霍乱等致死疾病。
因此,能够杀灭细菌的抗生素被誉为20世纪最伟大的发明,在过去80年里,仅青霉素就挽救了超过两亿人的生命。
但与此同时,细菌也对人类的健康大有裨益。每个人的表皮和肠道里都有上千亿的益生细菌以及其他微生物,统称为人类菌群。
它们不仅能帮助我们从食物中获取能量,这些“好”细菌有时候还会保护我们不受“坏”细菌侵袭。这是因为好细菌圆满就位后,坏细菌就无法占据我们的肠道。

电子显微镜下人类粪便培养出的细菌
一旦我们干扰了菌群,坏细菌可能就会入侵。长期使用抗生素的一个后果是,药力会杀死部分有益细菌,这时候艰难梭菌等致病细菌便会趁虚而入,导致我们腹泻、恶心以及发烧。
然而,在过去几十年的研究中,我们发现了一种神奇的疗法,可以治疗艰难梭菌造成的感染:把一位健康志愿者的粪便转移到患者的肠道内,其中的有益细菌可以战胜原有的艰难梭菌。
这种“粪便转移”疗法也可用于治疗其他疾病,但原理目前不详。
田纳西范德堡大学教授赛斯·博登斯坦(Seth Bordenstein)一直致力于研究动物微生物和病毒间的关系。他表示,粪便中哪种细菌带来了这种有益效应,我们无法确定。
我们可以在医学中精确运用一些细菌,因为我们了解其运作原理。大肠杆菌就是其中的典范,此菌寄生于人体,基本无害。
经过几十年来的研究,我们对大肠杆菌有了充分的了解,使其基本成为一个可编程的微型生物电脑,用于治疗各种疾病。
“有些益生菌品种的大肠杆菌可以搜寻癌变肿瘤,并在其内繁殖,因此它们可以成为适宜携带治疗癌症药物的载体。”纽约哥伦比亚大学博士生坎迪斯·戈巴特里(Candice Gurbatri)如是说。
戈巴特里与同在哥伦比亚大学的教授塔尔·丹尼诺(Tal Danino)协同研究细菌的肿瘤搜寻行为。他们在大肠杆菌中植入了一种额外的DNA,使其得以生成“纳米抗体”这种强大的抗癌分子。
另一种额外的DNA可促使大肠杆菌在肿瘤内增殖后自我销毁,使其含有的纳米抗体充斥癌变组织,从而使得这种形态的大肠杆菌在被肿瘤吞噬后,可以帮助锁定并消灭肿瘤。
今年年初,戈巴里特、丹尼诺及其同事在老鼠身上测试了这一方法,取得了可观成果。但在进行人体实验前,仍有一些老生常谈的问题亟待解决,即针对人体使用基因编辑的微生物在伦理和安全方面的考量,这一点可以理解。
2. 可再生能源
细菌是卓越的化学家,它们不仅可以制造抗癌药物,也可以用于大量生产可再生生物燃料。
今年早期,曼彻斯特大学的教授奈杰尔·斯克鲁顿(Nigel Scrutton)及其同事发表的一项研究揭示了这一前景。
他们编辑了一种名为“成纤维细胞活化蛋白”的蛋白酶,许多细菌中都有这种酶,它通过发酵分解人的食物垃圾,生成丙烷气体。丙烷可用于交通燃料,以及日常取暖做饭。
对于可持续发展的商业模式来说,这本身无疑是一个良好的开端,而斯克鲁顿及同事进一步提高了商业成功的可能性。他们将蛋白酶植入盐单胞菌中,这是一种少见的可在高浓度盐水中生存的细菌。
大多数工业发酵系统是由钢材建造的,必须仔细消毒,确保没有杂菌进入发酵罐降低效率。但是,由于盐单胞菌发酵系统在盐水中进行发酵,除盐单胞菌之外,基本上没有其他微生物可以存活下来,因此省去了昂贵的灭菌处理。
“你甚至可以在塑料制成的廉价反应器中完成发酵,”斯克鲁顿说,“这减少了资本投入。”

画家对于“空气发电设备”凭空制造电力的艺术畅想
细菌还可以通过多种其他方式制造生物燃料。
其中一种涉及到一些不寻常的菌种,它们通过进食和排泄电子(即携带负电荷的亚原子粒子)来发电。在适宜的环境中放入一个电极,这些具有电活性的细菌就会围绕电极进行生长繁殖。
马萨诸塞州大学的教授德里克·洛夫里(Derek Lovley)及其同事,多年来致力于研究如何将这些微生物用于生产可再生能源。
2010年,他们使卵形鼠抱菌长时间处于饥饿状态中,无法以它们最爱的氢分子为食,与此同时却给它们提供足够的电力。
最终,这些微生物改变了食谱,以电子为食,而且能利用电能将二氧化碳转化为醋酸盐,这是一种颇具商业价值的盐,可用于制造生物燃料和塑料。
洛夫里把这一过程叫做“微生物电合成法”,它生产生物燃料的潜力比农产品更大。
这是因为生物合成所需的电能可以来源于太阳能板,而这种获得太阳能的方法意外地比植物的光合作用更有效率,例如油菜籽,人们现今正以其作为生物燃料。
今年年初,洛夫里和同事展示了细菌帮人们生产可持续能源的另一种方法。一些有电活性的细菌会长出微小的可导电毛发,研究者拔下这些毛发,将其放于两个导电的金片中间,这种装置就能自然地产生电力。
这种“空气发电装置”直接从空气中获得电力,显然是依靠空气中的湿度差。洛夫里和其团队经过计算,认为大型空气发电机的优越性可以胜过太阳能板,且不需像太阳能板一样只在白天可用。
3. 污水
细菌是终极回收者。一直以来,人类都认为污水是废料,细菌却把它当成食物,这就是细菌在污水处理厂中举足轻重的原因。
但运营这种处理厂成本高昂。我们通常依靠好氧微生物来降解废物,即废水必须以气泵保持空气充盈,而该操作耗资巨大。
“也不是必须如此操作。”马萨诸塞州的寒武纪创新公司联合创始人兼首席执行官马修·西尔维(Matthew Silver)说,寒武纪公司发明了一种处理污水方法,使其产生的能源高于生产消耗的能源。
这种方法是可行的,西尔维表示,因为工业废水中蕴含大量能源。例如奶制品企业的废水中,含有大量碳水化合物和蛋白质。“复杂的碳水化合物,我们可把它当成燃料。”他说。
该公司的运行体系,依赖于可在无氧环境下繁殖的细菌,从而节省了空气泵的开支。在该系统中,包含地杆菌属和希瓦氏菌属等电活性细菌,可在水中进食杂质释放电子和其他带电粒子。
在系统的其他部分,产甲烷菌利用这些粒子为能量源,将二氧化碳转化为甲烷气体。“甲烷可以用于发热生电。”西尔维表示。

水处理厂依靠微生物降解废料
利用微生物同时进行污水处理与制造能源这一理念,始于15年前,但是将实验室中的演示转化为商业上的可行模式,还有些困难。
“污水中的能量密度较低,因此要产生高能量需要处理巨量的水,”纽约康奈尔大学教授巴兹·巴尔斯托(Buz Barstow )说,他从事细菌产能的可行性研究。
但西尔维认为,将该技术用于工业领域时,经济效益非常可观,因为工业废水通常比城市污水更富能源。
4. 食品
细菌可以养活全世界。除了可将二氧化碳转化为燃料外,还有一些氢营养菌,能将二氧化碳转化为可供人类食用的蛋白质。
事实上,这不足为奇。我们所食用的植物,都是通过太阳获得能量,将二氧化碳转化为碳水化合物。严格上说,植物的这种能力并非自身演化而来,而是通过把光合细菌融入自身细胞中得来的。
比起光合作用,太阳能板可以更高效地转化光能,由此引出了一个有趣的可能性:如果我们可以通过太阳能,让细菌将二氧化碳转化为蛋白质,我们可以使植物生长得比以前更快。
太阳能食品公司(Solar Foods),这家芬兰初创企业,致力于把这类非光合作用食品商品化。该公司首席执行官帕西·梵尼卡(Pasi Vainikka)博士表示,通过太阳能板产生的能量分解水分子,产生氢气。
然后,将细菌置于发酵器中以氢分子喂养。出于商业考虑,梵尼卡不愿透露他们使用的是哪种细菌。微生物以氢气作为能源,将大气中的二氧化碳转化为高质量的蛋白质,可替代目前饮食中的动物蛋白质。
“我们将食品生产与农业分离,”梵尼卡表示这么做颇有裨益,例如未来几年公司使用的发酵器占不了多大空间,“就像是开了一个酿酒厂吧。”他形容道。
即便发酵器必须和太阳能发电厂连接在一起,占地面积总和依然较小。根据梵尼卡的估算,只需传统牧场十二分之一大小的面积,就能生产等量的蛋白质。

光合作用细菌可以通过太阳能将二氧化碳转化为食物
这有助于退耕还林,吸收更多二氧化碳。“从系统层面来说,我们的碳排放是负数。”梵尼卡表示。
研究表明,通过细菌和微生物生产有益于地球生态的蛋白质前景广阔。
梵尼卡预期,未来公司的产品将作为食品添加剂,提高面包、意面以及燕麦奶这类植物饮料的蛋白质含量。
即使消费者的态度可能会褒贬不一,公司依然非常乐观。毕竟,多年以来,英国肉类替代品生产商(Quorn Foods)一直在销售由微生物生产的蛋白质,虽然他们是利用真菌而非细菌生产。
5. 气候变化
细菌虽然微小,却能减缓全球气候变化。这是因为许多菌种主要以温室气体二氧化碳为食。但这一设想有个缺陷:细菌进食二氧化碳的速度太慢了。
快速繁殖的菌种能够消耗更多的二氧化碳,但这类细菌更喜欢吃糖。去年,以色列魏茨曼科学研究所的罗恩·米洛(Ron Milo)教授以及其团队,展示了将快速繁殖菌种——大肠杆菌,转变为以二氧化碳为食的可能性。
米洛团队对大肠杆菌的基因进行了改造,插入消耗二氧化碳的光合细菌DNA,随即将大肠杆菌置于高浓度二氧化碳和几乎无糖的环境中。一年以后,大肠杆菌进化,以二氧化碳为食。
“我们的研究证明了一个理念:在给予一定时间后,常用菌种的代谢机制是可以发生改变的。”团队成员施缪尔·格雷泽尔(Shmuel Gleizer)博士说道。
格雷泽尔表示,从理论上来说,一个结合了大肠杆菌的太阳能板,消耗二氧化碳的效率是光合作用的10倍。
“我认为这是一项重大突破,”德国格里夫斯瓦尔德大学生物技术教授乌韦·伯恩斯伊尔(Uwe Bornscheuer)说,他未参与该研究。他补充道,通过研究的不断发展,这将为全球变暖带来积极影响,意义重大。

结合太阳能板和大肠杆菌的系统,可以更高效地净化大气中二氧化碳
其他科学家正在做“土地益生菌”实验,他们把精挑细选出来的微生物植入到土地中,既可提高土壤的碳储存能力,又能加速作物的生长。
一些研究人士宣称,土壤益生菌植入土地后,一公顷农田可多储存10吨二氧化碳。他们认为,这意味着世界上的农业用地具有吸收人类一年内所排放全部二氧化碳的潜能。
但这类研究颇具争议。澳大利亚南昆士兰大学生态学家亚当·傅鲁(Adam Frew)博士认为,问题在于我们并不足够了解土壤中微生物群落的确切本质,因此对它们进行有益改良是困难的。
“捷径是不存在的,”他说,微生物有提高土壤碳储存的潜力,但更好的方式是培养本已生活在土壤中的微生物,而不是添加新的。
6. 污染
细菌会吃掉几乎所有含碳的物质,有些细菌甚至适应了以油和其他类型的污染物为食。
“2010年,位于墨西哥湾的‘深水地平线’钻油平台发生漏油事故后,大量细菌随即在四周繁殖。”华盛顿大学密苏里圣路易斯分校微生物教授歌塔姆·丹泰斯(Gautam Dantas)如是说。
这种以油为食的能力并非无人注意,世界各地的研究者分析接近石油泄漏区土壤中的细菌群落,以分辨哪种细菌最擅长降解油污。一个设想是,可以将这些嗜油菌用于面临严重油污染问题的地方。
该方法的潜在问题是,我们对土壤中的细菌群落知之甚少,这点和农作物益生菌一样。
“外来的细菌恐怕要和本土细菌展开激烈竞争,”德国赫姆霍兹中心环境研究所教授赫曼·赫派珀(Hermann Heipieper)说。
但细菌仍然是清洁行动的重要一环。我们应记住更具意义的一点,那就是它们不断进化和适应新食物的惊人能力。

在“深水地平线”钻油平台发生漏油事故后,海上油膜出现了以油为食的细菌
如果工业工厂周边的土壤遭到油污染,其中的细菌有可能会进化,开始以油为食。我们可以为这些细菌提供其它养分,帮助它们保持健康,从而加速以油为食的速度。这种方法叫做“生物刺激”。
“这种方法通过定期加入含氮、磷、铁的废料实现。”赫派珀说。
将细菌进行基因编辑同样可行,这样它们可以将汞等重金属转化为低毒性形态,但将基因编辑后的生物投入自然存在伦理和安全方面的问题。
7. 塑料
细菌可不挑食。除了石油,它们也会食用以石油为原料制造的含碳产品,比如塑料。
2016年,一个日本团队去回收站收集聚对苯二甲酸乙二醇酯(PET)塑料样品,该物质常用于制作饮料瓶和衣物中的聚酯纤维。他们发现部分样本中存在以塑料为食的细菌。
这些微生物使用一对称为“PETase”和“MHETase”的生物酶,将塑料降解成更小的分子,如乙烯和乙二醇粒子,这些小分子可用于回收生产新塑料。研究者将此菌命名为Ideonella sakaiensis。
这一研究发现最令人惊奇的地方在于,塑料造成的自然污染还不到80年。“并没有用多长时间,这种细菌就进化到了可以食用这种新型人造含碳制品的地步。”伯恩斯伊尔(Bornscheuer)说。
Ideonella sakaiensis细菌进食塑料的速度很慢,但生物学家可以把细菌体内分解塑料的酶提取出来,对它的结构进行改造,从而提高它的工作效率。
2008年,朴茨茅斯大学的约翰·麦基汉(John McGeehan)教授率领团队改良了一种叫做I.sakaiensis PETase的酶,使其降解塑料的效率提高了近20%。他们现在正在探索和改良其他种类细菌酶的降解效率,使其适用于商业用途,处理各类污染环境的塑料。
今年早期发布的一项研究揭示了成功的可能性。法国“绿色化学” 公司(Carbios)的研究人员提取了以塑料为食的酶——叶枝堆肥角质酶——这种酶是从十年前的废料堆里分离出来的,然后在实验室中对其进行了结构改造。

PETase酶(蓝色)降解PET塑料(红白色)
正常来说,酶降解PET塑料需要花好几天的时间,而经过改造后的酶只需几个小时。研究人员用酶降解废弃PET塑料后,将降解后的成分重塑成塑料瓶,和先前由石油所制造的塑料瓶一模一样。
“这证明了一个重要原则,经过改造,酶可以帮助我们循环利用污染严重的塑料。”未参与该实验的麦基汉表示。
细菌不仅只食用PET塑料。今年早期,赫派珀及其团队在德国赫姆霍兹中心环境研究所找到了细菌可能会降解聚氨酯的证据,该物质用于制作隔热层和汽车零件。
“世界各地都有细菌降解塑料的报告,这令人振奋。”麦基汉说。
8. 抗生素
1928年,亚历山大·弗莱明(Alexander Fleming)发明了青霉素,这也是第一种抗生素。这一发明极其重要,人们至今仍依靠它来杀灭细菌保持健康。
但随着各种抗生素的诞生(尤其是过度使用),我们使抗生素遍布整个大环境,细菌从而有大量机会适应并进化出抗药性。令人惊讶的是,细菌或许刚巧帮我们解决了它们自己制造出来的麻烦,因为其中一些细菌以抗生素为食。
“我从事该研究十几年了,但当我发现这一点时依然十分震惊。”丹泰斯称。
2018年,丹泰斯及其团队发现了可以帮助土壤中细菌进食青霉素的酶。然后他们将这种能力转移到了寻常可见且基本无害的大肠杆菌上。
虽然有很多难关需要攻克,但丹泰斯表示,这种基因被编辑过的细菌最终很可能应用于污水处理站,来清除水中的抗生素。
或许最大的问题是微生物之间会交换DNA,所以人们担忧这一食用抗生素的基因最终传递给可造成危险疾病的细菌。这样一来,细菌会吃掉本该除灭它们的药物。
一些细菌产生了抗药性
但如果有足够的时间来改造细菌,研究者很有可能找到攻克难关的办法,将细菌转变为对付抗药性的重要武器。
想必这一理念对于那些了解细菌具备巨大潜能的人来说不会感到吃惊,毕竟我们已经让细菌面对众多挑战:从清除二氧化碳,降解塑料,处理环境污染,再到生产食物,净化水质,制造可再生能源,还有针对性的治疗癌症。
本文来自微信公众号:造就(ID:xingshu100),作者:Gabrielle,审校:田晓娜
相关推荐
“吃货”拯救世界,细菌如何通过吃吃吃拯救地球?
《Fast Company》评2019改变世界创意大奖:拯救地球的17个方案
科学家改造出“吃二氧化碳”的细菌,或能减轻温室效应
狗吃牛排、猫吃龙虾,1000万人天天围观别人的宠物吃饭
DNA和乳制品不兼容的蒙古人,如何拯救乳糖不耐?
叫好不叫座,苹果该如何拯救HomePod?
该如何拯救你,我那被手机碾碎的专注力
专“撸”电商的“吃货”群:面向学生收徒 提供造假服务
隐秘?混乱?商业化?探寻OpenAI“拯救世界”背后的真相
当「吃播」的罗永浩坐拥3000万精神股东
网址: “吃货”拯救世界,细菌如何通过吃吃吃拯救地球? http://www.xishuta.cn/newsview30588.html
推荐科技快讯
- 1问界商标转让释放信号:赛力斯 95792
- 2报告:抖音海外版下载量突破1 25736
- 3人类唯一的出路:变成人工智能 25175
- 4人类唯一的出路: 变成人工智 24611
- 5移动办公如何高效?谷歌研究了 24309
- 6华为 nova14深度评测: 13155
- 7滴滴出行被投诉价格操纵,网约 11888
- 82023年起,银行存取款迎来 10774
- 9五一来了,大数据杀熟又想来, 9794
- 10手机中存在一个监听开关,你关 9519
